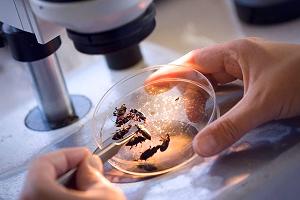
энтомология

Профессиональную переподготовку по энтомологии могут пройти:
- Специалисты со средним медицинским образованием или прошедшие курс профессиональной переподготовки по направлениям "Медико-профилактическое дело".
- Повышение квалификации не реже одного раза в 5 лет в течение всей трудовой деятельности
По окончании обучения по программе "Энтомология" слушатель получает диплом о профессиональной переподготовке
После прохождения курса профессиональной переподготовки необходимо проходить сертификационные циклы повышения квалификации не реже 1 раза в 5 лет.
По завершении обучения специалист может занимать должности:
- помощник энтомолога.
Информация о курсе
- Организатор:
- Единый Центр Дополнительного Профессионального Образования, г. Москва
- Тип курса:
- Профессиональная переподготовка
- Название курса:
- Курс энтомология
- Выдаваемый документ:
- Диплом о профессиональной переподготовке установленного гос. требованиями образца.
- Код программы:
- МЕД-С-ПП-35
- Форма обучения:
- Заочная (дистанционная), очная
- Начало обучения:
- Любой рабочий день
Получить информацию о курсе: энтомология
Выдаваемые документы выписываются и регистрируются в Москве, признаются на всей территории РФ и в других странах

Доступность
образования
Форма обучения с применением дистанционных образовательных технологий через Интернет или очно в группах.

В соответствии
с гос. стандартами
Получаете диплом о профессиональной переподготовке, соответствующий установленному образцу.

Рассрочка
платежа
Денежные средства можно вносить частями. Оплачивайте ежемесячно без процентов в 2-3 платежа.

Доставка документов
по России
После согласования документы направляются курьером или почтой с трек номером в течение 2-3 дней.
Курсы по медицине средний мед. персонал, стоимость и сроки обучения.
Программа обучения по курсу энтомология может иметь несколько вариантов продолжительности обучения в академических часах.
Профессиональная переподготовка по медицине средний мед. персонал может быть в стандартном режиме обучения и в ускоренном.
Выберите наиболее подходящий курс для медицинских работников в списке на сайте или позвоните по телефону.
Стоимость программы обучения курса по медицине средний мед. персонал зависит от выбранного количества часов и режима обучения.
Оставьте запрос информации о курсе в форме. С Вами свяжутся из приемной комиссии и подробно расскажут о возможных вариантах обучения!
Мы принимаем оплату за обучение: Банковские карты, онлайн переводы, электронные деньги, наличные в кассах партнеров, Яндекс Касса.





Процесс обучения
Поступление
Поступить и приступить к обучению можно в любой день!
Поступить на обучение может любой желающий, имеющий среднее профессиональное или высшее образование, а также студент старших курсов. Для начала обучения необходимо отправить заявку на обучение (выше на странице). С Вами свяжутся специалисты по сопровождению учебного процесса, ответят на все вопросы. Далее методический отдел утвердит возможность обучения и после этого мы направим Вам договор и счет. Далее Вам необходимо произвести оплату по счету в банке или в по реквизитам в платежной системе онлайн-банка. Все готово! Вы можете приступать к обучению!
Для поступления требуются в электронном (скан или фото) виде следующие документы:
- заявка и договор об обучении
- копия документа об образовании или справка об обучении (для студентов)
- документ о смене имени, отчества или фамилии (если фамилия, имя или отчество в заявке и дипломе не совпадают)
- для медицинских работников - интернатура, ординатура, дипломы о профессиональной переподготовке, крайний сертификат специалиста (при наличии)
Обучение
В процессе обучения у вас будет открыт доступ на учебный портал, где будут находиться все необходимые методические и учебные материалы. Вы сможете их изучать в онлайн режиме, посредством личного кабинета или скачать к себе на компьютер или мобильный телефон.
Все лекции представлены в PDF-формате, что очень удобно, ведь нет необходимости устанавливать дополнительные программы.
После завершения изучения учебных материалов, Вам необходимо пройти итоговое тестирование, по результатам которого вам будут поставлены оценки «зачет» или оценки за экзамен в приложении к диплому. Тестирование Вы можете пройти несколько раз, Вам будет предоставлено как минимум 3 попытки. Дополнительная плата во время обучения не взимается!
После успешной сдачи итогового тестирования Вы получите диплом о профессиональной переподготовке.
Выдача документов
После завершения обучения оригиналы документов Вы можете получить лично (забрать у нас в офисе) или мы направим Вам заказным письмом или курьерской службой. Адрес и форма получения оригиналов для направления документов указывается в заявке на обучение.
Наши дипломы и сертификаты оформляются в бумажном виде на бланках строгой отчётности с несколькими степенями защиты.
Вместе с дипломом выдаем договор и акт в бумажном виде.
В соответствии с законом об Образовании в РФ, диплом о проф. переподготовке может быть выдан слушателям, имеющим высшее или среднее профессиональное образование. Если слушатель не имеет такого образования, то ему мы можем выдать свидетельство о доп. образовании (а после получении среднего профессионального или высшего образования слушателю будет выдан диплом о профессиональной переподготовке).
Документы оформляются от 1 до 2 рабочих дней.
Государственная лицензия, заключения и сертификаты
Единый Центр Дополнительного Профессионального Образования имеет государственную лицензию на образовательную деятельность №038734.
Лицензия выдана Департаментом образования города Москвы и включена в реестр Рособрнадзора.
Вы можете быстро проверить лицензию на сайте Рособрнадзора.
Проверить